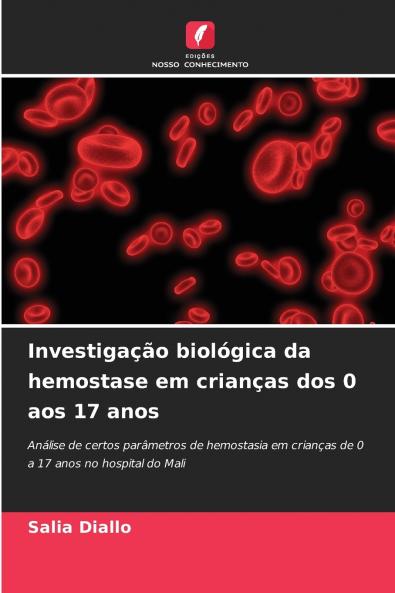
Investigação biológica da hemostase em crianças dos 0 aos 17 anos

Portuguese
Paperback
₹5634
₹7427
24.14% OFF
(All inclusive*)
Delivery Options
Please enter pincode to check delivery time.
*COD & Shipping Charges may apply on certain items.
Review final details at checkout.
Looking to place a bulk order? SUBMIT DETAILS
About The Book
Description
Author
A hemóstase engloba todos os mecanismos envolvidos na paragem da hemorragia. Quando um vaso sanguíneo é rompido a tarefa do organismo é repará-lo. Existem determinados parâmetros como o tempo de protrombina o rácio normalizado internacional e o tempo de tromboplastina parcial activada que desempenham um papel importante tanto no diagnóstico como na monitorização terapêutica desta patologia. O objetivo deste estudo foi investigar a hemostase em crianças dos 0 aos 17 anos de idade. Os parâmetros estudados foram a velocidade de protrombina (TP) o INR e o tempo de tromboplastina parcial activada ou caulínica (APTT/TCK) tendo sido incluídos 100 doentes dos quais 57% eram do sexo masculino e 43% do sexo feminino. A maioria destes doentes era oriunda da comuna 6 (61%) 16% da comuna 5 10% da periferia de Bamako (ou seja doentes de fora das comunas de Bamako) 8% da comuna 1 e 5% da comuna 4. No que diz respeito aos motivos de prescrição da hemostase verificou-se que este parâmetro foi prescrito nos doentes principalmente para avaliação pré-operatória (90% dos casos). Esta análise foi igualmente sugerida em caso de suspeita de infeção (4%).
Delivery Options
Please enter pincode to check delivery time.
*COD & Shipping Charges may apply on certain items.
Review final details at checkout.
Details
ISBN 13
9786208924607
Publication Date
-31-05-2025
Pages
-56
Weight
-90 grams
Dimensions
-152x229x3.41 mm